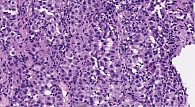

Использование PRAME в диагностике меланоцитарных образований
- Аннотация
- Статья
- Ссылки
- English

![Таблица 2. Предложенная Olds H. и соавт. [5] методика оценки экспрессии PRAME в образованиях, ассоциированных с повышенным уровнем инсоляции](/upload/resize_cache/iblock/dc8/195_350_1/Prokopenko2.jpg)

Введение
PRAME (PReferentially expressed Antigen in MElanoma) – опухоль-ассоциированный антиген, впервые выявленный путем клонирования аутологичного эпитопа Т-клеток у пациентов с метастатической меланомой кожи. Нативная экспрессия PRAME в клетках здоровых органов крайне ограничена и представлена интактными тканями яичка, яичника, плаценты, эндометрием и надпочечниками. Помимо кожной меланомы, впоследствии экспрессия данного маркера была обнаружена в увеальной меланоме, а также в некоторых других немеланоцитарных опухолях: синовиальной саркоме, немелкоклеточном раке легкого, почечно-клеточном раке, миксоидной липосаркоме и др. [1].
В то время как «золотым стандартом» морфологической диагностики меланоцитарных образований остается исследование срезов, окрашенных гематоксилин-эозином, иммуногистохимия остается важным вспомогательным методом диагностики, особенно в спорных случаях. Использование такого маркера, как PRAME, в ряде зарубежных исследований [1–3] продемонстрировало достаточную эффективность в диагностике меланом различных локализаций, в т.ч. и метастатического генеза. По данным мировой литературы, от 83,2% до 94% первичных кожных меланом неверетеноклеточной морфологии демонстрируют диффузную экспрессию PRAME, в то время как большинство невусов (86%) негативны по данному маркеру [1–3]. Внутри кластера меланом различных кожных локализаций способность к экспрессии PRAME наблюдалась у 94,4% акральных меланом, 92,5% поверхностно-распространяющихся меланом, 90% узловых меланом, 88,6% меланом по типу злокачественного лентиго, 35% десмопластических меланом [1]. Помимо этого, позитивны по экспрессии PRAME до 87% метастатических меланом. Также в ряде зарубежных исследований установлена прямая корреляция между результатами молекулярно-генетического FISH – исследования с определением копийности генов RREB1/MYB/CEP6/CCND1 и иммуногистохимической экспрессии маркера PRAME. В частности, были установлены конкордантность результатов описанных исследований в 90% случаев и конкордантность между результатами иммуногистохимического исследования и окончательного диагноза в 92,7% [2].
Все вышеперечисленное демонстрирует потенциальную перспективность использования PRAME в качестве вспомогательного диагностического маркера в ряде дискутабельных случаев. В нашем исследовании была поставлена цель проанализировать экспрессию маркера PRAME в ряде различных меланоцитарных образований, а также сопоставить полученные финальные результаты с данными мировой литературы.
Материал и методы
В ходе исследования проанализированы 33 случая, включающих в себя как первичные меланоцитарные новообразования кожи и анального канала, так и метастазы меланомы. Первичные образования включали в себя: невусы различных локализаций и морфологий, солярное лентиго, злокачественные лентиго, поверхностно-распространяющиеся меланомы, меланому анального канала, акральную меланому.
Все проведенные иммуногистохимические реакции были поставлены с использованием Anti-PRAME Rabbit Monoclonal Primary Antibody (mAb EPR20330; Abcam, #219650) на платформе Ventana BenchMark ULTRA system с системой визуализации (ultraView Universal Alkaline Phosphatase Red Detection Kit и UltraView Universal DAB Detection Kit). В качестве внутреннего контроля расценивалась мембранно-цитоплазматическая экспрессия в себоцитах сальных желез.
Оценка результатов каждого случая проводилась коллегиально с участием трех врачей-патологоанатомов.
Критерии оценки экспрессии PRAME
Критерием оценки уровня экспрессии маркера PRAME была выбрана система, предложенная C. Lezcano и соавт. [1] (табл. 1).
Обоснованием выбора является то, что большинство опухолей с окрашиванием 1+ показали редкие, случайно распределенные позитивные ядра, в то время как большинство опухолей с окрашиванием 4+ демонстрировали практически тотальную положительную экспрессию.
В некоторых случаях, где опухоль демонстрировала выраженную гетерогенность по PRAME, результат считался положительным при наличии как минимум двух смежных полей зрения (×400) диффузного уровня экспрессии (не менее 75% клеток с ядерным окрашиванием) [4]. При этом общий процент окрашивания клеток опухоли мог быть менее 75%. Согласно Alomari A.K. и соавт., описанный паттерн экспрессии рассматривался как позитивный [4]. Оценка экспреcсии PRAME в случаях образований, ассоциированных с повышенным уровнем инсоляции, в т.ч. злокачественного лентиго, производилась по методу, предложенному Olds H. и соавт. [5] (табл. 2).
Оценка краев резекции в случаях злокачественного лентиго является крайне неоднозначным вопросом, представляющим определенные диагностические трудности. Наиболее утилитарным авторы статьи расценили метод, предложенный Gradecki S.E. и соавт. Упомянутые авторы определяли позитивный край резекции следующим образом: «грязным» край резекции считался в том случае, если в его пределах отмечалось два и более подряд расположенных меланоцита с позитивной ядерной экспрессией PRAME. Единичные редкие или дискретно расположенные клетки с экспрессией PRAME не рассматривались в качестве позитивного края по злокачественному лентиго, так как такой паттерн экспрессии ранее был отмечен в 15% случаев солнечного лентиго [6].
Оценка экспрессии маркера PRAME в меланомах аноректальной зоны остается дискутабельной вследствие отсутствия достаточного количества материалов литературы, а также редкости заболевания.
Результаты
Очевидные случаи
В данном исследовании было проанализировано 14 первичных меланом различных локализаций, 12 из которых демонстрировали яркую (4+) диффузную (более 75% клеток) экспрессию маркера PRAME, что коррелировало с данными светооптического исследования. Таким образом, 85,7% исследованных первичных злокачественных меланоцитарных образований оказались PRAME-позитивными. Также было исследовано 15 невусов, в т.ч. невус Шпиц и невус особой локализации (молочная железа), показавших негативную экспрессию по маркеру PRAME. В четырех из четырех (100%) описанных случаев метастатической меланомы наблюдалась диффузная экспрессия PRAME 4+ более чем в 75% клеток опухоли (рис. 1.1 и 1.2).
Солярное лентиго vs злокачественное лентиго
Одной из потенциально трудных областей диагностики меланоцитарных опухолей кожи остается дифференциальная диагностика злокачественного лентиго и доброкачественных образований, ассоциированных с повышенным уровнем солярного повреждения, в частности солярного лентиго. Хроническая инсоляция вызывает увеличение количества эпидермальных меланоцитов, что в некоторых случаях затрудняет диагностику злокачественного лентиго. В ходе исследования было проанализировано три случая, два из которых по результатам сочетания рутинного светооптического исследования с иммуногистохимическим окрашиванием антителом PRAME представлены солярным лентиго и один случай – злокачественным лентиго.
Случай № 1
Пациентка М., 57 лет, рецидивирующее пигментное образование крыла носа по типу пятна с нечеткими, неровными контурами. Произведена панч-биопсия. В пределах срезов, окрашенных гематоксилин-эозином, в базальном слое определяется скопление клеток, подозрительных на меланоцитарные, в одном из кусочков – небольшие гнездные скопления невоидных клеток (рис. 2.1). При проведении иммуногистохимического исследования с маркером PRAME определяется диффузное окрашивание интенсивностью 4+ примерно в 63 клетках на протяженности 1 мм, расцененное авторами статьи как злокачественное лентиго. Полученный результат согласуется с литературными данными и вышеприведенным предложенным методом оценки уровня экспрессии (рис. 2.2) [5].
Случай № 2
Пациентка Г., 67 лет, слабопигментное образование по типу пятна на скуловой области. Произведена панч-биопсия. По результатам рутинного светооптического исследования определяются единичные, дискретно расположенные, несколько увеличенные в размерах меланоциты в пределах юнкциональной зоны (рис. 3.1). Результаты иммуногистохимического исследования с маркером PRAME (рис. 3.2) демонстрируют аберрантную цитоплазматическую экспрессию в базальных пигментных кератиноцитах и ядерную экспрессию интенсивностью 4+ в юнкциональных меланоцитах, количество которых составляет шесть клеток на протяжении 1 мм, что расценивается авторами статьи как простое солярное лентиго.
Случаи с неоднозначной экспрессией PRAME
Случай № 3
Пациентка К., 65 лет, образование по типу пятна на коже плечевой области, 4 × 3 мм (рис. 4.1). По данным дерматоскопии было вынесено заключение о неопределенном потенциале злокачественности образования (рис. 4.2). По данным светооптического исследования срезов, окрашенных гематоксилин-эозином (рис. 4.3), принадлежность опухоли к слабопигментной поверхностно-распространяющейся эпителиоидноклеточной меланоме не вызывает сомнений. Определялись отсутствие вертикального созревания клеток, цитологическая и ядерная атипия, выраженный полиморфизм клеток по периферии опухоли, митотическая активность. Однако уровень экспрессии PRAME демонстрирует гетерогенность по интенсивности окрашивания: от 1+ до 4+ (рис. 4.4). В данном случае авторы исследования использовали вышеприведенный метод оценки гетерогенной экспрессии PRAME и расценили приведенный на рис. 4.4 паттерн экспрессии в качестве позитивного.
Случай № 4
Пациентка Б., 66 лет, образование на коже спины по типу узла, 4 х 4 мм (рис. 5.1). Светооптически (рис. 5.2), а также с учетом проведенного иммуногистохимического исследования с маркерами р16 (негативная реакция, рис. 5.3), HMB45 (неравномерная «пятнистая» экспрессия без признаков градиентности, рис. 5.4), повышенного индекса пролиферации Ki67 (до 35% в hot spots, рис. 5.5) окончательный диагноз – слабопигментная смешанно-клеточная меланома кожи в стадии вертикального роста. Образование показывает отсутствие убедительной экспрессии маркера PRAME с учетом неоднократных ротаций иммуногистохимического исследования (рис. 5.6). Однако определяется экспрессия в меланоцитах юнкциональной зоны (рис. 5.7), что не расценивалось авторами статьи в качестве диагностически значимого критерия.
Меланома анального канала
Меланома анального канала – редкое заболевание, составляющее 0,05% всех злокачественных новообразований колоректальной области и 0,3% всех меланом [7].
В ходе данного исследования авторы статьи проанализировали случай изъязвленной меланомы прямой кишки в узловой стадии роста.
Случай № 5
Пациентка Г., 65 лет, с наличием образования диаметром около 1 см по задней стенке прямой кишки на 3 см от анального канала. Выполнено трансанальное удаление опухоли.
В пределах гистологических препаратов, окрашенных гематоксилин-эозином, определяется рост опухоли, имеющей строение инвазивной эпителиоидноклеточной малопигментной меланомы (рис. 6.1.1). Также определяются фокусы лентигинозного роста меланомы in situ (рис. 6.1.2). По данным иммуногистохимического исследования, диффузная (более 75% опухолевых клеток) экспрессия PRAME как в пределах инвазивного компонента, так и в пределах лентигинозной меланомы in situ (рис. 6.2.1; рис. 6.2.2), что потенциально расширяет области применения данного маркера.
Заключение
Иммуногистохимическое исследование с маркером PRAME продемонстрировало достаточную эффективность в качестве метода вспомогательной диагностики меланоцитарных образований различного генеза и локализаций. Несмотря на это, остаются случаи, в которых уровень наблюдаемой экспрессии расходится с ожидаемым и остается дискутабельным. В рамках нашего исследования было проанализировано 33 случая меланоцитарных образований как первичного, так и метастатического генеза. В двух случаях наблюдалось тотальное отсутствие экспрессии PRAME в образованиях, чья принадлежность к меланоме не вызывает сомнений и диагностируется на светооптическом уровне. Еще в трех образованиях, светооптически также расцененных как злокачественные, клетки опухоли демонстрировали выраженную гетерогенность экспрессии PRAMЕ. Проанализировав полученные результаты, можно сделать вывод, что 84,8% всех исследованных меланом демонстрировали диффузную яркую экспрессию маркера PRAMЕ, в то время как 100% невусов были негативны по этому маркеру. Таким образом, полученные в ходе исследования результаты соотносятся с данными мировой литературы.
Несмотря на тот факт, что в большем проценте случаев результаты иммуногистохимического исследования с маркером PRAME успешно коррелировали с окончательным диагнозом, использование других антител (р16, HMB45, Ki67), а также применение молекулярно-генетических методов не теряет своей актуальности.
V.A. Prokopenko, Ya.V. Vishnevskaya, PhD, O.A. Zaspa
N.N. Blokhin National Medical Research Center of Oncology, Moscow
Contact person: Victoria Alekseevna Prokopenko, v.prokopenko@ronc.ru
Immunohistochemical examination of melanocytic formations remains an important auxiliary diagnostic method, especially in controversial cases. The use of such a marker as PRAME demonstrated sufficient effectiveness in the diagnosis of melanomas of various localizations (84.8% of all primary and secondary melanomas of various morphological types studied showed diffuse bright expression of the PRAME marker, while nevi (some below the threshold value) were negative for this marker. However, there are cases in which the level of observed expression differs from the expected one and remains controversial, which limits the possibility of using the PRAME marker as a monodiagnostic immunohistochemical marker.
Уважаемый посетитель uMEDp!
Уведомляем Вас о том, что здесь содержится информация, предназначенная исключительно для специалистов здравоохранения.
Если Вы не являетесь специалистом здравоохранения, администрация не несет ответственности за возможные отрицательные последствия, возникшие в результате самостоятельного использования Вами информации с портала без предварительной консультации с врачом.
Нажимая на кнопку «Войти», Вы подтверждаете, что являетесь врачом или студентом медицинского вуза.